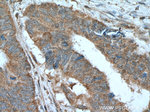
LIPH Antibody in Immunohistochemistry (Paraffin) (IHC (P))

Search
Proteintech
LIPH Monoclonal Antibody (1F5D10)
{{$productOrderCtrl.translations['antibody.pdp.commerceCard.promotion.promotions']}}
{{$productOrderCtrl.translations['antibody.pdp.commerceCard.promotion.viewpromo']}}
{{$productOrderCtrl.translations['antibody.pdp.commerceCard.promotion.promocode']}}: {{promo.promoCode}} {{promo.promoTitle}} {{promo.promoDescription}}. {{$productOrderCtrl.translations['antibody.pdp.commerceCard.promotion.learnmore']}}
产品信息
66303-1-IG
种属反应
宿主/亚型
分类
类型
克隆号
抗原
偶联物
形式
浓度
规格
纯化类型
保存液
内含物
保存条件
运输条件
产品详细信息
Immunogen sequence: VVVVDWNRG ATTLIYTHAS SKTRKVAMVL KEFIDQMLAE GASLDDIYMI GVSLGAHISG FVGEMYDGWL GRITGLDPAG PLFNGKPHQD RLDPSDAQFV DVIHSDTDAL GYKEPLGNID FYPNGGLDQP GCPKTILGGF QYFKCDHQRS VYLYLSSLRE SCTITAYPCD SYQDYRNGKC VSCGTSQKES CPLLGYYADN WKDHLRGKDP PMTKAFFDTA EESPFCMYHY FVDIITWNKN VRRGDITIKL RDKAGNTTES KINHEPTTFQ KYHQVSLLAR FNQDLDKVAA ISLMFSTGSL IGPRYKLRIL RMKLRSLAHP ERPQLCRYDL VLMENVETVF QPILCPELQL (103-451 aa encoded by BC064941)
靶标信息
This gene encodes a membrane-bound member of the mammalian triglyceride lipase family. It catalyzes the production of 2-acyl lysophosphatidic acid (LPA), which is a lipid mediator with diverse biological properties that include platelet aggregation, smooth muscle contraction, and stimulation of cell proliferation and motility.
仅用于科研。不用于诊断过程。未经明确授权不得转售。
生物信息学
蛋白别名: Lipase member H; lipase, member H; LIPH; LPD lipase-related protein; Membrane-associated phosphatidic acid-selective phospholipase A1-alpha; membrane-bound phosphatidic acid-selective phospholipase A1; mPA-PLA1; mPA-PLA1 alpha; phospholipase A(1); Phospholipase A1 member B; unnamed protein product
基因别名: AH; ARWH2; HYPT7; LAH2; LIPH; LPDLR; mPA-PLA1; MPAPLA1; PLA1B
UniProt ID: (Human) Q8WWY8
Entrez Gene ID: (Human) 200879, (Pig) 100737989